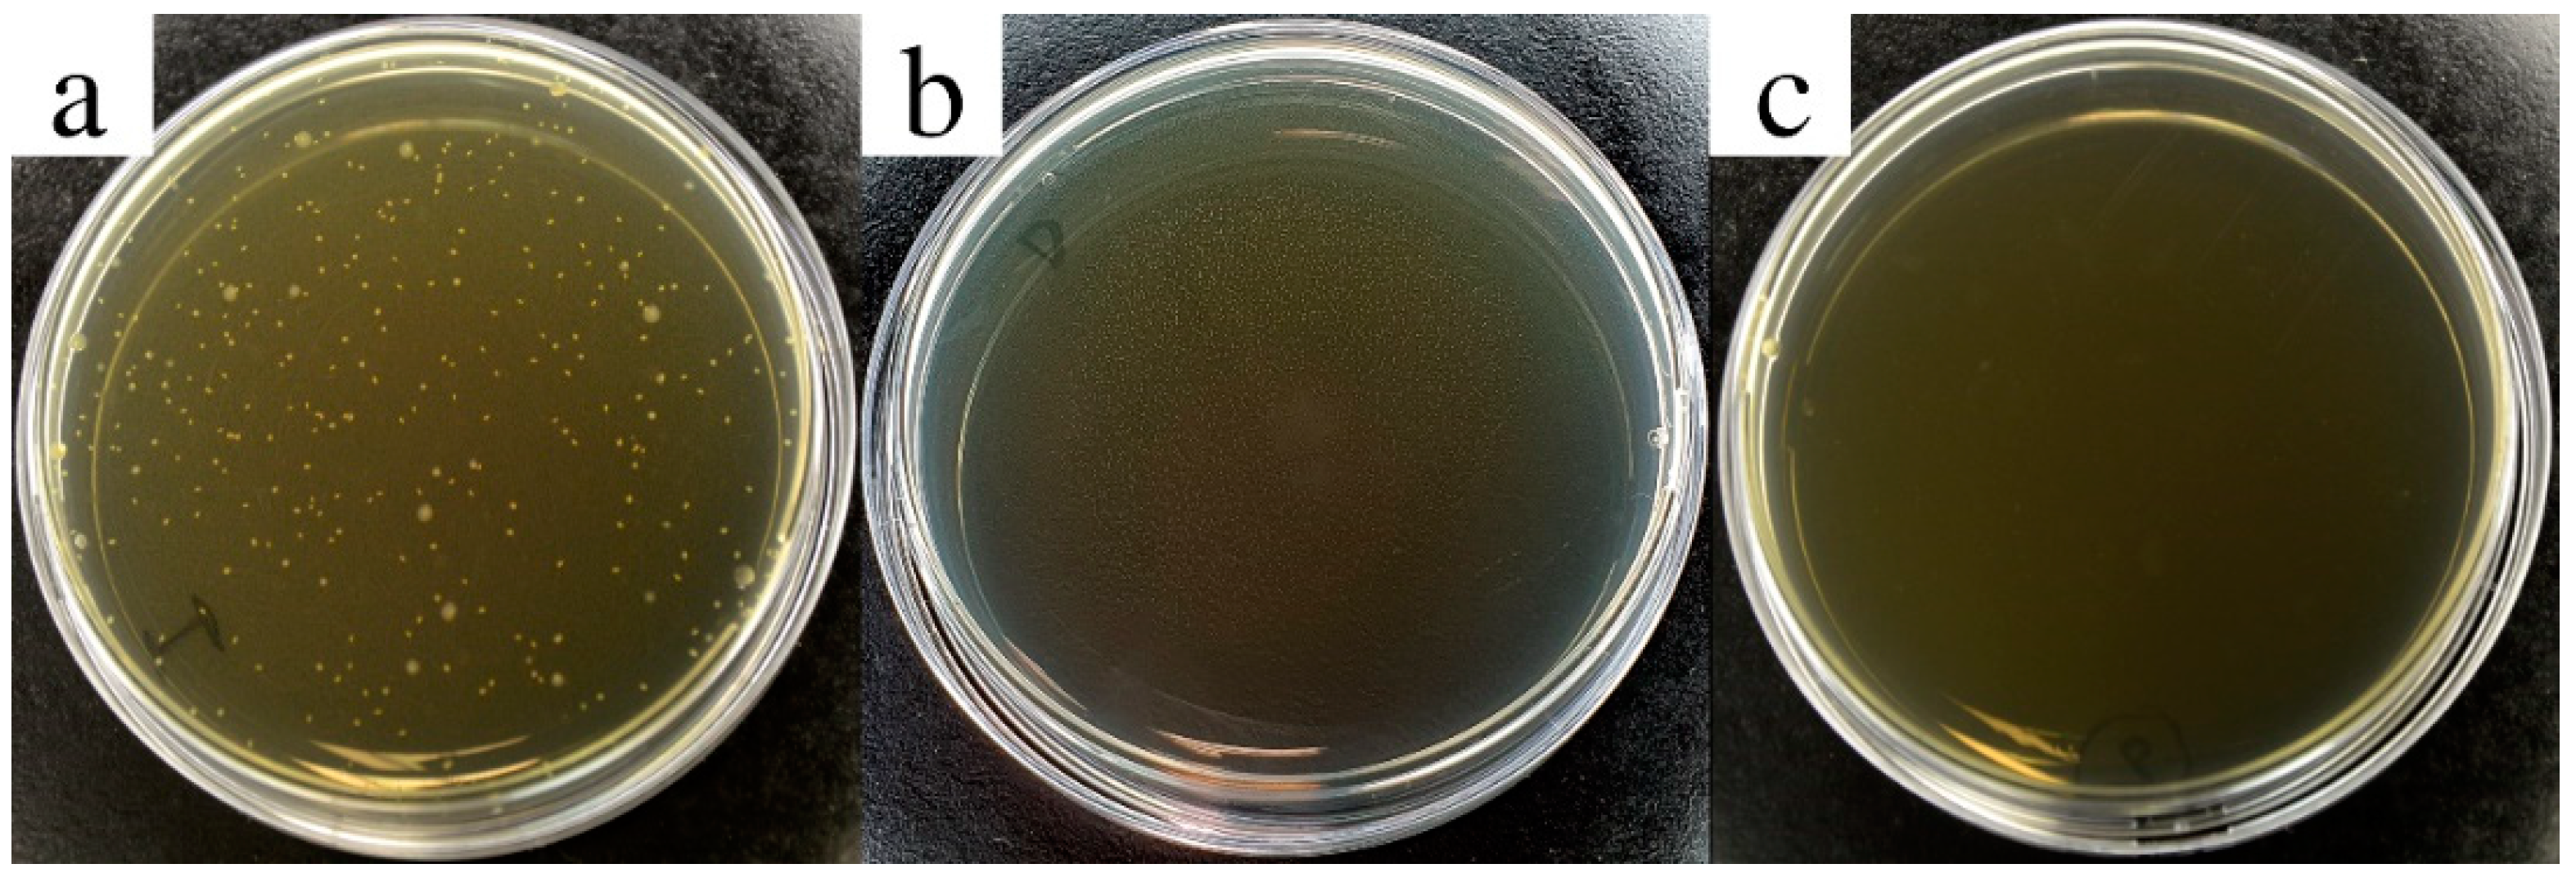
Nanomaterials 11 01991 g003

Safety Assessment of Polypyrrole Nanoparticles and Spray-Coated Textiles
Abstract
1. Introduction
2. Materials and Methods
2.1. Polypyrrole Synthesis
2.2. PPy NPs Spray Deposition on Fabrics
2.3. NPs and NPs-Coated Textiles’ Characterization
2.4. Washing Test
2.5. Antibacterial Efficacy Analysis
2.6. Preparation of Textile Extracts
2.7. In Vitro Toxicological Analyses
2.7.1. Cell Cultures’ Maintenance
2.7.2. Cell Viability of Monocultures Exposed to NPs
2.7.3. Co-Culture Model of the Air–Blood Barrier: Toxicity Endpoints
- −
- cell barrier integrity and functionality by the measurement of the transepithelial electrical resistance (TEER),
- −
- cell viability by the colorimetric assay Alamar Blue test, and
- −
- release of inflammatory cytokines, IL-8 and IL-6, by ELISA test.
2.7.4. The Reconstructed Human Epidermis Model EpiDerm™
2.7.5. Corrosion Test on EpiDerm™
2.7.6. Irritation Test on EpiDerm™
2.7.7. Interleukin-8 Quantification from EpiDerm™ Model
2.8. Statistical Analysis
3. Results and Discussion
3.1. PPy NPs’ Characterization
3.2. Characterization of PPy-Coated Textiles
3.3. Antibacterial Efficiency of PPy
3.4. Toxicity of PPy NPs on In Vitro Models
3.4.1. Cell Viability of A549 Lung Cells and Balb/3T3 Fibroblast Monocultures
3.4.2. Effects of PPy NPs on In Vitro Air–Blood Barrier
3.4.3. Toxicity of PPy NPs and Textile Extracts on Reconstructed Human Epidermis
4. Conclusions
Author Contributions
Funding
Institutional Review Board Statement
Informed Consent Statement
Data Availability Statement
Acknowledgments
Conflicts of Interest
References
- Saleem, H.; Zaidi, S.J. Sustainable Use of Nanomaterials in Textiles and Their Environmental Impact. Materials 2020, 13, 5134. [Google Scholar] [CrossRef]
- Talikowska, M.; Fu, X.; Lisak, G. Application of Conducting Polymers to Wound Care and Skin Tissue Engineering: A Review. Biosens. Bioelectron. 2019, 135, 50–63. [Google Scholar] [CrossRef]
- Petkova, P.; Francesko, A.; Perelshtein, I.; Gedanken, A.; Tzanov, T. Simultaneous Sonochemical-Enzymatic Coating of Medical Textiles with Antibacterial ZnO Nanoparticles. Ultrason. Sonochem. 2016, 29, 244–250. [Google Scholar] [CrossRef]
- Pullangott, G.; Kannan, U.; Gayathri, S.; Kiran, D.V.; Maliyekkal, S.M. A Comprehensive Review on Antimicrobial Face Masks: An Emerging Weapon in Fighting Pandemics. RSC Adv. 2021, 11, 6544–6576. [Google Scholar] [CrossRef]
- Lee, N.-Y.; Ko, W.-C.; Hsueh, P.-R. Nanoparticles in the Treatment of Infections Caused by Multidrug-Resistant Organisms. Front. Pharmacol. 2019, 10, 1153. [Google Scholar] [CrossRef] [PubMed]
- Malka, E.; Perelshtein, I.; Lipovsky, A.; Shalom, Y.; Naparstek, L.; Perkas, N.; Patick, T.; Lubart, R.; Nitzan, Y.; Banin, E.; et al. Eradication of Multi-Drug Resistant Bacteria by a Novel Zn-Doped CuO Nanocomposite. Small 2013, 9, 4069–4076. [Google Scholar] [CrossRef]
- Mackevica, A.; Foss Hansen, S. Release of Nanomaterials from Solid Nanocomposites and Consumer Exposure Assessment—A Forward-Looking Review. Nanotoxicology 2016, 10, 641–653. [Google Scholar] [CrossRef]
- Perelshtein, I.; Lipovsky, A.; Perkas, N.; Gedanken, A.; Moschini, E.; Mantecca, P. The Influence of the Crystalline Nature of Nano-Metal Oxides on Their Antibacterial and Toxicity Properties. Nano Res. 2015, 8, 695–707. [Google Scholar] [CrossRef]
- Varesano, A.; Vineis, C.; Aluigi, A.; Rombaldoni, F.; Tonetti, C.; Mazzuchetti, G. Antibacterial Efficacy of Polypyrrole in Textile Applications. Fibers Polym. 2013, 14, 36–42. [Google Scholar] [CrossRef]
- Sparavigna, A.C.; Florio, L.; Avloni, J.; Henn, A. Polypyrrole Coated PET Fabrics for Thermal Applications. Mater. Sci. Appl. 2010, 1, 253. [Google Scholar] [CrossRef]
- Da Silva, F.A.G.; Queiroz, J.C.; Macedo, E.R.; Fernandes, A.W.C.; Freire, N.B.; da Costa, M.M.; de Oliveira, H.P. Antibacterial Behavior of Polypyrrole: The Influence of Morphology and Additives Incorporation. Mater. Sci. Eng. C Mater. Biol. Appl. 2016, 62, 317–322. [Google Scholar] [CrossRef]
- Vaitkuviene, A.; Kaseta, V.; Voronovic, J.; Ramanauskaite, G.; Biziuleviciene, G.; Ramanaviciene, A.; Ramanavicius, A. Evaluation of Cytotoxicity of Polypyrrole Nanoparticles Synthesized by Oxidative Polymerization. J. Hazard. Mater. 2013, 250–251, 167–174. [Google Scholar] [CrossRef] [PubMed]
- Huang, Z.-B.; Yin, G.-F.; Liao, X.-M.; Gu, J.-W. Conducting Polypyrrole in Tissue Engineering Applications. Front. Mater. Sci. 2014, 8, 39–45. [Google Scholar] [CrossRef]
- Fahlgren, A.; Bratengeier, C.; Gelmi, A.; Semeins, C.M.; Klein-Nulend, J.; Jager, E.W.H.; Bakker, A.D. Biocompatibility of Polypyrrole with Human Primary Osteoblasts and the Effect of Dopants. PLoS ONE 2015, 10, e0134023. [Google Scholar] [CrossRef] [PubMed]
- Balint, R.; Cassidy, N.J.; Cartmell, S.H. Conductive Polymers: Towards a Smart Biomaterial for Tissue Engineering. Acta Biomater. 2014, 10, 2341–2353. [Google Scholar] [CrossRef]
- Gan, D.; Shuai, T.; Wang, X.; Huang, Z.; Ren, F.; Fang, L.; Wang, K.; Xie, C.; Lu, X. Mussel-Inspired Redox-Active and Hydrophilic Conductive Polymer Nanoparticles for Adhesive Hydrogel Bioelectronics. Nano-Micro Lett. 2020, 12, 169. [Google Scholar] [CrossRef]
- Xie, C.; Li, P.; Han, L.; Wang, Z.; Zhou, T.; Deng, W.; Wang, K.; Lu, X. Electroresponsive and Cell-Affinitive Polydopamine/Polypyrrole Composite Microcapsules with a Dual-Function of on-Demand Drug Delivery and Cell Stimulation for Electrical Therapy. NPG Asia Mater. 2017, 9, e358. [Google Scholar] [CrossRef]
- Almeida, L.; Ramos, D. Health and Safety Concerns of Textiles with Nanomaterials. IOP Conf. Ser. Mater. Sci. Eng. 2017, 254, 102002. [Google Scholar] [CrossRef]
- Sanchez Ramirez, D.O.; Varesano, A.; Carletto, R.A.; Vineis, C.; Perelshtein, I.; Natan, M.; Perkas, N.; Banin, E.; Gedanken, A. Antibacterial Properties of Polypyrrole-Treated Fabrics by Ultrasound Deposition. Mater. Sci. Eng. C Mater. Biol. Appl. 2019, 102, 164–170. [Google Scholar] [CrossRef]
- Bengalli, R.; Colantuoni, A.; Perelshtein, I.; Gedanken, A.; Collini, M.; Mantecca, P.; Fiandra, L. In Vitro Skin Toxicity of CuO and ZnO Nanoparticles: Application in the Safety Assessment of Antimicrobial Coated Textiles. NanoImpact 2021, 21, 100282. [Google Scholar] [CrossRef]
- Zerboni, A.; Bengalli, R.; Baeri, G.; Fiandra, L.; Catelani, T.; Mantecca, P. Mixture Effects of Diesel Exhaust and Metal Oxide Nanoparticles in Human Lung A549 Cells. Nanomaterials 2019, 9, 1302. [Google Scholar] [CrossRef]
- Bengalli, R.; Mantecca, P.; Camatini, M.; Gualtieri, M. Effect of Nanoparticles and Environmental Particles on a Cocultures Model of the Air-Blood Barrier. BioMed Res. Int. 2013, 2013, 801214. [Google Scholar] [CrossRef]
- Kandárová, H.; Hayden, P.; Klausner, M.; Kubilus, J.; Sheasgreen, J. An in Vitro Skin Irritation Test (SIT) Using the EpiDerm Reconstructed Human Epidermal (RHE) Model. J. Vis. Exp. 2009, 29, e1366. [Google Scholar] [CrossRef]
- Bengalli, R.; Gualtieri, M.; Capasso, L.; Urani, C.; Camatini, M. Impact of Zinc Oxide Nanoparticles on an in Vitro Model of the Human Air-Blood Barrier. Toxicol. Lett. 2017, 279, 22–32. [Google Scholar] [CrossRef]
- OECD ILibrary|Test No. 431: In Vitro Skin Corrosion: Reconstructed Human Epidermis (RHE) Test Method. Available online: https://www.oecd-ilibrary.org/environment/test-no-431-in-vitro-skin-corrosion-reconstructed-human-epidermis-rhe-test-method_9789264264618-en (accessed on 17 June 2021).
- Test No. 439: In Vitro Skin Irritation: Reconstructed Human Epidermis Test Method. Available online: https://www.oecd-ilibrary.org/environment/test-no-439-in-vitro-skin-irritation_9789264090958-en (accessed on 17 June 2021).
- Tsai, C.S.-J. Contamination and Release of Nanomaterials Associated with the Use of Personal Protective Clothing. Ann. Occup. Hyg. 2015, 59, 491–503. [Google Scholar] [CrossRef]
- Kang, C.; Kim, S.S.; Ahn, D.; Kim, S.J.; Lee, J. Effective Surface Attachment of Ag Nanoparticles on Fibers Using Glycidyltrimethylammonium Chloride and Improvement of Antimicrobial Properties. RSC Adv. 2017, 7, 23407–23414. [Google Scholar] [CrossRef]
- Varesano, A.; Belluati, A.; Ramirez, D.O.S.; Carletto, R.A.; Vineis, C.; Tonetti, C.; Songia, M.B.; Mazzuchetti, G. A Systematic Study on the Effects of Doping Agents on Polypyrrole Coating of Fabrics. J. Appl. Polym. Sci. 2016, 133. [Google Scholar] [CrossRef]
- Kulthong, K.; Srisung, S.; Boonpavanitchakul, K.; Kangwansupamonkon, W.; Maniratanachote, R. Determination of Silver Nanoparticle Release from Antibacterial Fabrics into Artificial Sweat. Part. Fibre Toxicol. 2010, 7, 8. [Google Scholar] [CrossRef]
- Von Goetz, N.; Lorenz, C.; Windler, L.; Nowack, B.; Heuberger, M.; Hungerbühler, K. Migration of Ag- and TiO2-(Nano)Particles from Textiles into Artificial Sweat under Physical Stress: Experiments and Exposure Modeling. Environ. Sci. Technol. 2013, 47, 9979–9987. [Google Scholar] [CrossRef]
- Lombi, E.; Donner, E.; Scheckel, K.G.; Sekine, R.; Lorenz, C.; Goetz, N.V.; Nowack, B. Silver Speciation and Release in Commercial Antimicrobial Textiles as Influenced by Washing. Chemosphere 2014, 111, 352–358. [Google Scholar] [CrossRef]
- Kim, S.; Oh, W.-K.; Jeong, Y.S.; Hong, J.-Y.; Cho, B.-R.; Hahn, J.-S.; Jang, J. Cytotoxicity of, and Innate Immune Response to, Size-Controlled Polypyrrole Nanoparticles in Mammalian Cells. Biomaterials 2011, 32, 2342–2350. [Google Scholar] [CrossRef] [PubMed]
- Peng, Z.; Qin, J.; Li, B.; Ye, K.; Zhang, Y.; Yang, X.; Yuan, F.; Huang, L.; Hu, J.; Lu, X. An Effective Approach to Reduce Inflammation and Stenosis in Carotid Artery: Polypyrrole Nanoparticle-Based Photothermal Therapy. Nanoscale 2015, 7, 7682–7691. [Google Scholar] [CrossRef]
- Coquette, A.; Berna, N.; Vandenbosch, A.; Rosdy, M.; De Wever, B.; Poumay, Y. Analysis of Interleukin-1α (IL-1α) and Interleukin-8 (IL-8) Expression and Release in in Vitro Reconstructed Human Epidermis for the Prediction of in Vivo Skin Irritation and/or Sensitization. Toxicol. Vitr. 2003, 17, 311–321. [Google Scholar] [CrossRef]
- Phan, T.T.V.; Bui, N.Q.; Moorthy, M.S.; Lee, K.D.; Oh, J. Synthesis and In Vitro Performance of Polypyrrole-Coated Iron–Platinum Nanoparticles for Photothermal Therapy and Photoacoustic Imaging. Nanoscale Res. Lett. 2017, 12, 570. [Google Scholar] [CrossRef] [PubMed]
- Mahat, M.M.; Sabere, A.S.M.; Azizi, J.; Amdan, N.A.N. Potential Applications of Conducting Polymers to Reduce Secondary Bacterial Infections among COVID-19 Patients: A Review. Emergent Mater. 2021, 4, 279–292. [Google Scholar] [CrossRef]
- Ivanova, V.T.; Garina, E.O.; Burtseva, E.I.; Kirillova, E.S.; Ivanova, M.V.; Stejskal, J.; Sapurina, I.Y. Conducting Polymers as Sorbents of Influenza Viruses. Chem. Pap. 2017, 71, 495–503. [Google Scholar] [CrossRef]

| NPs | Medium | Z-Average (nm) ± SD | PdI ± SD |
|---|---|---|---|
| PPy | mQ water | 331 ± 0.1 | 0.226 ± 0.013 |
| DMEM 1% FBS | 241 ± 2.1 | 0.235 ± 0.025 | |
| Opti-MEM 1% FBS | 252 ± 8.3 | 0.232 ± 0.026 |
| ISO 150 Washing Cycles | g PPy/m2 |
|---|---|
| 0 | 3.07 ± 0.21 |
| 1 | 3.13 ± 0.10 |
| 5 | 3.04 ± 0.10 |
| 10 | 3.09 ± 0.11 |
| 25 | 2.97 ± 0.12 |
Publisher’s Note: MDPI stays neutral with regard to jurisdictional claims in published maps and institutional affiliations. |
© 2021 by the authors. Licensee MDPI, Basel, Switzerland. This article is an open access article distributed under the terms and conditions of the Creative Commons Attribution (CC BY) license (https://creativecommons.org/licenses/by/4.0/).
Share and Cite
Bengalli, R.; Fiandra, L.; Vineis, C.; Sanchez-Ramirez, D.O.; Azoia, N.G.; Varesano, A.; Mantecca, P. Safety Assessment of Polypyrrole Nanoparticles and Spray-Coated Textiles. Nanomaterials 2021, 11, 1991. https://doi.org/10.3390/nano11081991
Bengalli R, Fiandra L, Vineis C, Sanchez-Ramirez DO, Azoia NG, Varesano A, Mantecca P. Safety Assessment of Polypyrrole Nanoparticles and Spray-Coated Textiles. Nanomaterials. 2021; 11(8):1991. https://doi.org/10.3390/nano11081991
Chicago/Turabian StyleBengalli, Rossella, Luisa Fiandra, Claudia Vineis, Diego Omar Sanchez-Ramirez, Nuno G. Azoia, Alessio Varesano, and Paride Mantecca. 2021. "Safety Assessment of Polypyrrole Nanoparticles and Spray-Coated Textiles" Nanomaterials 11, no. 8: 1991. https://doi.org/10.3390/nano11081991
APA StyleBengalli, R., Fiandra, L., Vineis, C., Sanchez-Ramirez, D. O., Azoia, N. G., Varesano, A., & Mantecca, P. (2021). Safety Assessment of Polypyrrole Nanoparticles and Spray-Coated Textiles. Nanomaterials, 11(8), 1991. https://doi.org/10.3390/nano11081991

